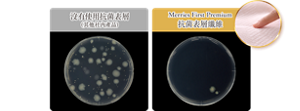
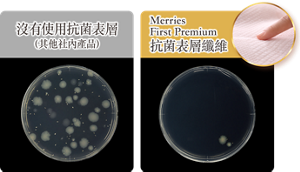

給寶寶5星級的極緻呵護
Merries First Premium選用最優質的材質
呵護寶寶幼嫩肌膚。

日本首創*抗菌表層`
有效抑制99.9%細菌滋生#

圖片為 JIS(L 1902:2015)測試結果
*指Merries品牌中首創,並使用日本Mintel嬰兒紙尿片數據及其他相關資料作研究。(2023年2月) `指表層纖維加入抗菌成份 #大腸桿菌及金黃葡萄球菌



2倍鬆軟Cashmere觸感^
面層如羊絨般柔滑 給寶寶肌膚最極緻舒適的呵護 ^ 外層部分與其他花王產品比較



100%超透氣材質※ 令肌膚持續乾爽
將引起尿布疹原因之一的濕氣和悶熱感排走 ※ 不包含黏貼膠帶部份



波浪綿點面層 薘鬆空氣感綿點輕柔接觸肌膚,
徹底吸收軟便,防止擴散滲漏
乾爽不回滲,極緻呵護幼嫩肌膚



添加天然護膚成份,
摩洛哥堅果油 與寶寶肌膚接觸的面層含有
有機高純度油



參考圖片



・以上圖案只供參考,應以實物為準
・每包只限1款圖案

初生碼
出生至5公斤
66片

細碼
4-8公斤
60 片

中碼
6-11公斤
48片




寶寶慢慢長大,開始四處翻滾或爬行

當寶寶開始活躍,於更換紙尿片時不停扭動身體

當紙尿片穿著妥當後,寶寶看上去仍感覺不舒服

需經常再三調整紙尿片魔術貼

柔軟緊貼腰圍! 完美貼合寶寶肚仔及大腿
為好動寶寶而設

超彈力腰圍,能伸展高達2.5倍※超彈性腰圍可伸展高達2.5倍!
不會太緊及讓寶寶感到舒適
容易穿著! ※ 與伸展前之比較 (根據花王調查)
參考圖片
參考圖片
利用黏貼膠帶捲起尿片
縮少尿片體積,方便棄置

*膠帶伸延部分長達10厘米 *如果膠帶伸延多於10厘米,或會造成斷裂

・以上圖案只供參考,應以實物為準
・每包只限2款圖案

中碼
6-11公斤
46片

大碼
9-14公斤
36片

加大碼
12-22公斤
32片